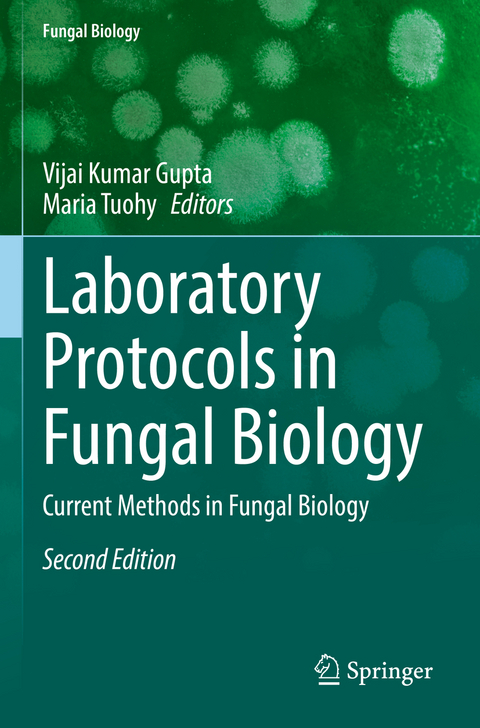
Laboratory Protocols in Fungal Biology -

Laboratory Protocols in Fungal Biology
Springer International Publishing (Verlag)
978-3-030-83751-8 (ISBN)
Mycology has an integral role to play in the development of the biotechnology and biomedical sectors. It has become a subject of increasing importance as new fungi and their associated biomolecules are identified. As this discipline comes to the forefront of research in these sectors, the requirement for a consolidation of available research approaches is required. The First Edition of this book has a few basic and applied protocols. With the Second Edition, this book provides consolidated information on recent developments and the most widely used mycological methods available in the fields of biochemistry, biotechnology and microbiology. The methods outlined offer clear and concise directions to the reader and covers both standard protocols and more applied mycological methods. This book provides useful information for undergraduates, post-graduates, and specialists and researchers studying fungal biology.
Vijai Kumar Gupta is currently working as Senior Fellow at Center for Safe and Improved Foods & Biorefining and Advanced Materials Research Center, Scotland’s Rural College (SRUC), Edinburgh, UK. Dr Gupta received his doctoral degree in Microbiology in 2009 from Dr RML Avadh University India, and the leading expert in the area of Biomass Valorisation, Microbial Bioprocess Biotechnologies, Bioactive Natural Products, and Environmental Sustainability. He is the Secretary of the European Mycological Association and also the International Professor at IFST-China, Visiting Professor at SCBG-China; SZIU-Hungary; SHUATS-India. Dr Gupta is the Fellow of few international scientific societies including- Linnaean Society-UK; Mycological Society of India; Indian Mycological Association; Academy of Microbiological Sciences India; National Academy of Agricultural Sciences, India and Member of Royal Society Biology, UK. He has 175 peer-reviewed publications, 33 book chapters and 39 books in his hands with author h-index 50, i10-index 173 with total 11K+ citations to-date. Also, he is the editor of few reputed journals including, Microbial Cell Factories, Scientific Reports, Microbiome, Biotechnology Advances and Critical Reviews in Biotechnology. Maria Tuohy is the Principal Investigator and Head of the Molecular Glycobiotechnology Group, School of Natural Sciences, NUI, Galway, Ireland. Dr. Tuohy has a strong track record in Glycobiotechnology and Enzyme Biotechnology, with ~28 years’ experience in fungal biology and biotechnology. A special focus of the research is on developing enabling technology for bioconversion of terrestrial plants and algae for biorefinery and bioenergy applications. This research encompasses protein biotechnology, molecular enzymology, proteomics, fungal genetics, biology and genomics, fermentation, analytical methods in glycobiology and protein biochemistry, development of novel energy systems, as well as key analytical methods to measure and characterize novel bioactive compounds from microbial, plant and marine sources. Understanding fungal biodiversity and the relationships between fungi and other organisms (terrestrial plants and marine life) forms a central theme that underpins the research on developing fungi as cell factories for production of enzymes and bioactives of biotechnological relevance. Research to date has involved ongoing collaboration with industry. Dr. Tuohy is one of 5 PIs in the EI-IDA supported, industry-led, national Technology Centre for Biorefining and Bioenergy (TCBB) and more recently, TCBB Resource. Through TCBB is involved in the European Bio- based Industries Consortium (BIC) and was a PI on the Technological Innovation work package of an EU FP7 INTERREG IVB NWE Programme (‘ReNEW’), which was coordinated by The Queens University Belfast and involved a consortium of RTD, Industry and regional development organizations across NW Europe. Dr. Tuohy is also a co-PI on Pillar 5 of the recent national Dairy Processing Technology Centre (DPTC; €25m funding), since February 2015, and a collaborating PI in the recent SFI- Industry supported ‘Sustainable Energy & Fuel Efficiency Spoke’ in MaREI Research Centre. Dr. Tuohy & her group are members of the Energy Research Centre and Environmental Technologies PRA group, Ryan Institute, NUI Galway, Ireland. Dr. Tuohy has successfully mentored 33 PhD students to completion to-date, and was awarded a prestigious President’s Award for Teaching Excellence in 2011-2012 by NUI Galway, Ireland.
Preface.- Long Term Preservation of Fungal Cultures in All-Russian Collection of Microorganisms (VKM): Protocols and Results.- Confocal Laser and Epifluorescence Microscopy.- Diagnose of Chytid Parasites of Algae in The Plankton.- Sabouraud Agar for Fungal Growth.- FISH, Fluorescence in Situ Hybridization of Uncultured Zoosporic Fungi.- Real-time Quantitative PCR Assay for Counting Uncultured Zoosporic Fungi.- Real-Time PCR Assay in Fungi.- Rapid Identification and Detection of Pathogenic Fungi by Padlock Probes.- Extraction and Characterization of Taxol: An Anticancer Drug from an Endophytic And Pathogenic Fungi.- Recent Advances in Applications of Machine Learning in Fungal Biology.- Fungal Conservation.- TBD.- Loop-Mediated Isothermal Amplification of the Entomopathogenic Fungi, Beauveria bassiana.- Molecular Taxonomy and Multi-Gene Phylogeny of Fungi.- Yeast Isolation Methods from Specialized Habitats.- Assays for the Quantification of Antioxidant Enzymes in Fungi.- Index.
| Erscheinungsdatum | 06.02.2023 |
|---|---|
| Reihe/Serie | Fungal Biology |
| Zusatzinfo | VI, 261 p. 24 illus., 15 illus. in color. |
| Verlagsort | Cham |
| Sprache | englisch |
| Maße | 155 x 235 mm |
| Gewicht | 415 g |
| Themenwelt | Naturwissenschaften ► Biologie ► Botanik |
| Naturwissenschaften ► Biologie ► Genetik / Molekularbiologie | |
| Naturwissenschaften ► Biologie ► Mikrobiologie / Immunologie | |
| Naturwissenschaften ► Biologie ► Mykologie | |
| Schlagworte | Biotechnology • Diagnostics • enzymes • fungal biology • Gene and PCR • Microscopy • Mycology • Plant sciences |
| ISBN-10 | 3-030-83751-3 / 3030837513 |
| ISBN-13 | 978-3-030-83751-8 / 9783030837518 |
| Zustand | Neuware |
| Informationen gemäß Produktsicherheitsverordnung (GPSR) | |
| Haben Sie eine Frage zum Produkt? |
aus dem Bereich


